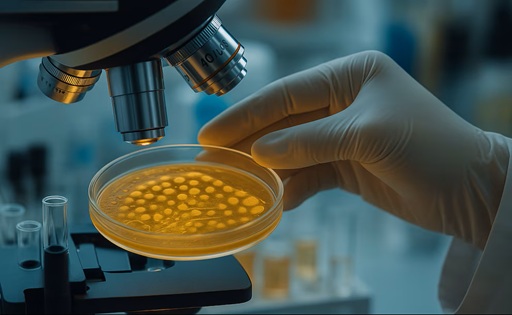
ANMAT y SENASA alertan por un lote específico de queso con Listeria

ANMAT y SENASA alertaron por un lote puntual de queso con Listeria. El producto fue retirado y no afecta al resto de la industria láctea.
Alerta sanitaria por un lote puntual de queso
La Administración Nacional de Medicamentos, Alimentos y Tecnología Médica (ANMAT) emitió una alerta preventiva tras la detección de la bacteria Listeria monocytogenes en un lote específico de queso de pasta blanda Cremón doble crema, marca La Serenísima, elaborado por Mastellone Hnos. S.A.
La advertencia se refiere exclusivamente al lote 2703, correspondiente a un envase de 500 gramos, elaborado el 3 de julio de 2025 y con fecha de vencimiento 11 de septiembre de 2025, ya fuera de circulación comercial al momento de la comunicación oficial.
Qué producto está involucrado
Según el informe técnico del Servicio Nacional de Sanidad y Calidad Agroalimentaria (SENASA), la bacteria fue detectada en muestras remitidas al Laboratorio Nacional de Referencia del Instituto Malbrán, en el marco de los sistemas de vigilancia genómica y control permanente que rigen sobre la industria alimentaria.
Datos del producto alcanzado por la alerta:
-
Producto: Queso Cremón doble crema
-
Marca: La Serenísima
-
Presentación: 500 g
-
Lote: 2703
-
Fecha de elaboración: 03/07/2025
-
Vencimiento: 11/09/2025
-
Establecimiento: B-I-05184 – Mastellone Hnos. S.A.
-
Ubicación: Trenque Lauquen, provincia de Buenos Aires
Medidas adoptadas por la empresa y el sistema sanitario
Bajo supervisión de SENASA, la empresa realizó:
-
Investigación interna para identificar el foco de contaminación
-
Retiro total del lote del mercado nacional
-
Destrucción del producto afectado
-
Refuerzo de los controles preventivos, sin detección de nuevos casos
Desde las autoridades sanitarias remarcaron que no se trata de un problema generalizado, sino de un evento acotado, detectado gracias al funcionamiento de los sistemas de control y trazabilidad del sector lácteo argentino.
Qué es la listeriosis y a quiénes afecta
La listeriosis es una enfermedad causada por el consumo de alimentos contaminados con Listeria monocytogenes, una bacteria que puede desarrollarse incluso a temperaturas de refrigeración, pero que se elimina con la cocción.
Los grupos de mayor riesgo son:
-
Mujeres embarazadas
-
Personas inmunosuprimidas
-
Adultos mayores
-
Recién nacidos
En personas sanas, los síntomas suelen ser leves o inexistentes, mientras que en poblaciones vulnerables pueden presentarse cuadros más graves.
Recomendaciones oficiales
ANMAT recomendó que quienes puedan conservar el lote 2703 del producto, incluso congelado, se abstengan de consumirlo y lo descarten.
Como medidas generales de prevención, las autoridades recuerdan:
-
Mantener higiene adecuada al manipular alimentos
-
Respetar fechas de vencimiento
-
Consumir lácteos pasteurizados
-
Conservar los alimentos en condiciones apropiadas
Un mensaje clave para el consumidor
Desde el sistema sanitario se destacó que este caso demuestra la eficacia de los controles oficiales y privados en la cadena láctea argentina. La detección temprana, el retiro inmediato del producto y la comunicación transparente refuerzan la confianza en los lácteos como alimentos seguros y regulados.
Fuente: Infobae